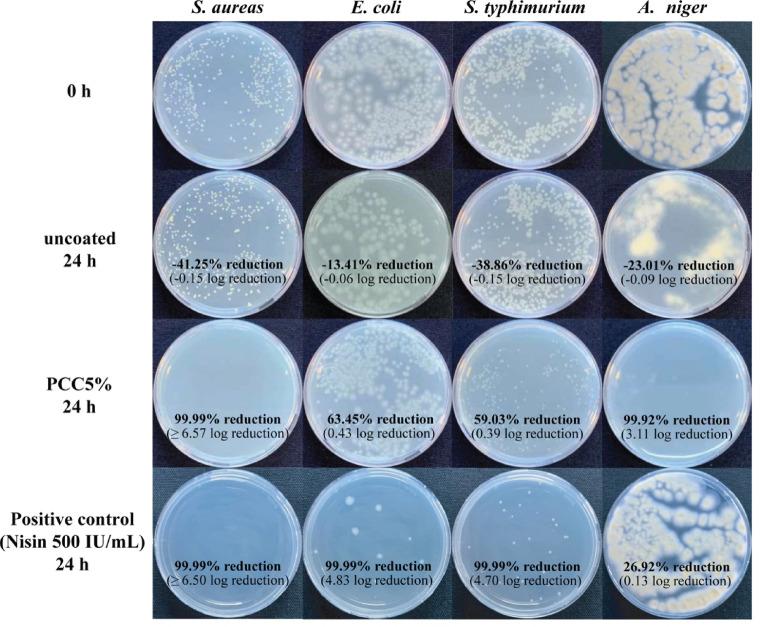
https://cdn.ncbi.nlm.nih.gov/pmc/blobs/385e/12267409/971ce4aeccda/41598_2025_10306_Fig5_HTML.jpg

表面涂覆有经季铵化有机硅烷改性的纳米纤维素和沉淀碳酸钙的纸包装,用于提高疏水性和抗菌活性。
Surface-coated paper packaging with nanocellulose modified with quaternary ammonium organosilane and precipitated calcium carbonate for improved water repellency and antibacterial activity.
作者信息
Somsesta Noppon, Chamamporn Chokchai, Wongsopanakun Napadol, Sonaka Phimmada, Hongrattanavichit Intatch
机构信息
Department of Military Materials Science, Academic Faculty, Navaminda Kasatriyadhiraj Royal Air Force Academy, Saraburi, Thailand.
Department of Imaging and Printing Technology, Faculty of Science, Chulalongkorn University, Bangkok, Thailand.
出版信息
Sci Rep. 2025 Jul 16;15(1):25723. doi: 10.1038/s41598-025-10306-5.
The widespread use of non-biodegradable plastic packaging has raised environmental and health concerns, prompting the development of sustainable alternatives. This study presents a functional paper coating composed of nanocellulose (CNFs) derived from hemp agricultural waste and modified with octadecyldimethyl(3-trimethoxysilylpropyl) ammonium chloride (ODDMAC). The modified CNFs were combined with varying concentrations of precipitated calcium carbonate (PCC) to enhance coating performance. Structural modifications were confirmed by FTIR and solid-state ¹³C-NMR, indicating the presence of alkyl and siloxane groups. Among all formulations, the PCC5%-coated paper exhibited optimal performance, with a highly hydrophobic surface (water contact angle > 150°), a significantly reduced Cobb60 value (24.45 ± 0.62 g/m²), and a low water vapor permeability (WVP) of 225.20 g·mm/m²·day·kPa, consistent with its enhanced hydrophobicity. FE-SEM analysis revealed a uniform 3 μm-thick coating layer with well-dispersed PCC particles contributing to surface roughness. The coated paper also showed improved tensile strength, excellent rub resistance (200 cycles), and strong antimicrobial activity, with reductions of Staphylococcus aureus and fungi by 99.99% and 99.92%, respectively. Biocompatibility was confirmed by 100% Caco-2 cell viability, and biodegradability reached 72.63% within 60 days. These findings demonstrate the potential of PCC5%-coated paper as a high-performance, safe, and eco-friendly alternative to plastic-based food packaging.
不可生物降解塑料包装的广泛使用引发了环境和健康方面的担忧,促使人们开发可持续的替代品。本研究展示了一种功能性纸张涂层,该涂层由源自大麻农业废弃物的纳米纤维素(CNFs)组成,并用十八烷基二甲基(3 - 三甲氧基硅丙基)氯化铵(ODDMAC)进行了改性。将改性后的CNFs与不同浓度的沉淀碳酸钙(PCC)混合,以提高涂层性能。通过傅里叶变换红外光谱(FTIR)和固态¹³C - 核磁共振(NMR)证实了结构改性,表明存在烷基和硅氧烷基团。在所有配方中,涂有5% PCC的纸张表现出最佳性能,具有高度疏水的表面(水接触角> 150°),显著降低的科布60值(24.45±0.62 g/m²),以及225.20 g·mm/m²·day·kPa的低水蒸气透过率(WVP),这与其增强的疏水性一致。场发射扫描电子显微镜(FE - SEM)分析显示有一层均匀的3μm厚涂层,PCC颗粒分散良好,有助于表面粗糙度。涂覆后的纸张还表现出提高的拉伸强度、优异的耐磨性能(200次循环)和强大的抗菌活性,金黄色葡萄球菌和真菌的减少率分别为99.99%和99.92%。通过100%的Caco - 2细胞活力证实了生物相容性,并且在60天内生物降解率达到72.63%。这些发现表明,涂有5% PCC的纸张作为塑料基食品包装的高性能、安全且环保的替代品具有潜力。